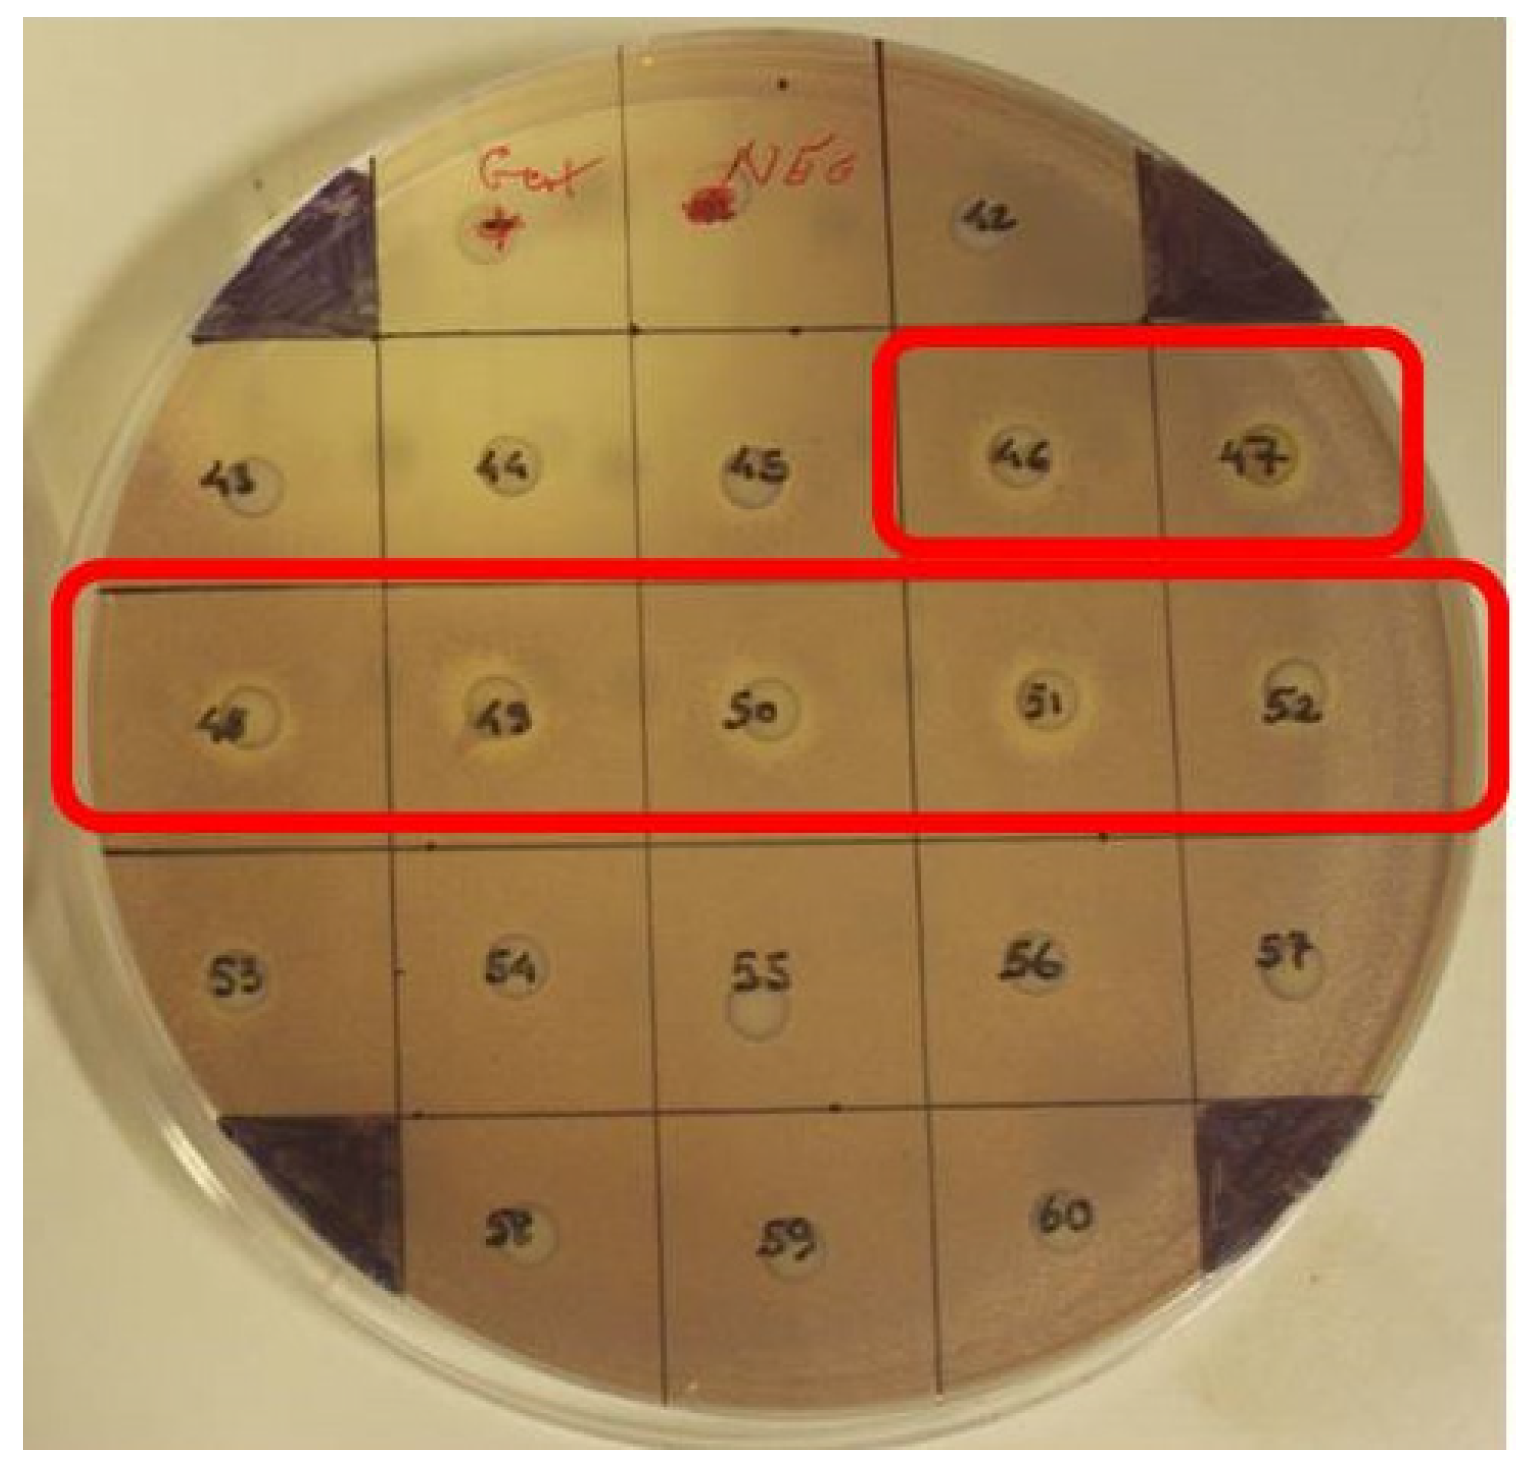

Antibiofilm Activity of the Brown Alga Halidrys siliquosa against Clinically Relevant Human Pathogens
Abstract
:1. Introduction
2. Results

2.1. MIC, MBC and MBEC Values of Extract E3
| Pathogenic Strain | MIC (mg/mL) | MBC (mg/mL) | MBEC (mg/mL) |
|---|---|---|---|
| S. aureus ATCC 29213 | 0.3125 | 0.3125 | NoA |
| S. aureus NCTC 12981 (ATCC 25923) | 0.1562 | 0.3125 | NT |
| S. aureus MRSA ATCC 33593 | 0.1562 | 0.1562 | 1.25 |
| S. aureus MRSA NCTC 10442 | 0.1562 | 0.3125 | 5 |
| S. aureus MRSA ATCC 43300 | 0.3125 | 0.3125 | NoA |
| S. epidermidis ATCC 35982 | 0.1562 | 0.3125 | NT |
| S. epidermidis NCTC 13360 (ATCC 12228) | 0.1562 | 0.3125 | NoA |
| S. epidermidis MRSE NCTC 11964 | 0.625 | 1.25 | NoA |
| S. haemolyticus NCTC 11042 | 0.1562 | 0.3125 | NoA |
| S. hominis NCTC 11320 | 0.3125 | 0.3125 | NoA |
| S. pyogenes NCTC 8306 (ATCC 12204) | 0.0391 | 0.0391 | NoA |
| S. agalactiae NCTC 8542 | 0.1562 | 0.1562 | NT |
| S. pneumoniae NCTC 7465 | 0.0391 | 0.0781 | NT |
| S. sanguinis NCTC 7863 | NoA | NoA | NoA |
| E. faecalis ATCC 779 | 0.3125 | 0.625 | NoA |
| P. mirabilis ATCC 7002 | 1.25 | NoA | NoA |
| P. aeruginosa PAO1 | 2.5 | 5 | NoA |
| P. aeruginosa NCTC 12903 (ATCC 27853) | 2.5 | 5 | NT |
| S. maltophilia NCTC 10257 (ATCC 13637) | 0.3125 | 0.625 | NoA |
| E. coli NCTC 12241 | 5 | 5 | NT |
| C. violaceum ATCC 12472 | 0.1562 | 0.3125 | NoA |
| C. albicans | NoA | NoA | NoA |

2.2. CLSM of S. aureus (MRSA) ATCC 33593 Biofilms Challenged with H. siliquosa Extract E3
2.3. Extract Toxicity Screen Using the Galleria Mellonella Model
2.4. Normal Phase Flash Chromatography/Bioassay Guided Fractionation
2.5. HPLC Analysis of Fractions
2.6. Screening Fresh H. siliquosa Fronds for Antimicrobial and QSI Activity


2.7. Disc Diffusion Assays Using Halidrys siliquosa Extracts

| Pathogenic Strain | E5 | CIP1 | P1 | TE10 | CN10 | Extract E3 (4 mg/mL) |
|---|---|---|---|---|---|---|
| S. aureus ATCC 29213 | (−) | 19 mm | 9 mm | 22 mm | 16 mm | 11 mm |
| S. aureus NCTC 12981 (ATCC 25923) | 19 mm | (−) | 11 mm | (−) | 16 mm | 11.5 mm |
| S. aureus MRSA ATCC 33593 | (−) | 19 mm | (−) | (−) | 8 mm | 13.5 mm |
| S. aureus MRSA NCTC 10442 | (−) | 18 mm | (−) | (−) | 16 mm | 13 mm |
| S. aureus MRSA ATCC 43300 | (−) | 16 mm | 8 mm | 18 mm | 9 mm | 10.5 mm |
| S. epidermidis ATCC 35982 | (−) | 26 mm | (−) | 22 mm | 14 mm | 13.5 mm |
| S. epidermidis NCTC 13360 (ATCC 12228) | 21 mm | 22 mm | (−) | (−) | 20 mm | 12 mm |
| S. epidermidis MRSE NCTC 11964 | 11 mm | (−) | (−) | (−) | (−) | 7 mm |
| S. haemolyticus NCTC 11042 | 18 mm | 20 mm | (−) | (−) | 16 mm | 13.5 mm |
| S. hominis NCTC 11320 | 27 mm | 25 mm | 26 mm | (−) | 26 mm | 10 mm |
| S. pyogenes NCTC 8306 (ATCC 12204) | (−) | 26 mm | (−) | 20 mm | 15 mm | 15 mm |
| S. agalactiae NCTC 8542 | 20 mm | 15 mm | 11 mm | 21 mm | 17 mm | 13 mm |
| P. mirabilis ATCC 7002 | (−) | 26 mm | (−) | (−) | 16 mm | 6 mm |
| P. aeruginosa PAO1 | (−) | 19 mm | (−) | (−) | 18 mm | 0 mm |
| S. maltophilia NCTC 10257 (ATCC 13637) | (−) | 30 mm | (−) | 16 mm | 20 mm | 10 mm |
| E. coli NCTC 12241 | 18 mm | 14 mm | 11 mm | 27 mm | 19 mm | 10 mm |
| C. violaceum ATCC 12472 | 20 mm | 32 mm | (−) | 25 mm | 20 mm | 12 mm |
| C. albicans | n.a. | n.a. | n.a. | n.a. | n.a. | 0 mm |
2.8. TLC Overlay Assays
3. Discussion
4. Experimental Section
4.1. Bacterial Strains Used in This Study
4.2. Galleria Mellonella Larvae Used in the in Vivo Toxicity Study
4.3. Chemicals and Reagents
4.4. Sample Collection
4.5. Screening Fresh H. siliquosa for Antimicrobial and QSI Activity
4.6. Solvent Extraction of Halidrys siliquosa
4.7. Screening for Antimicrobial Activity—Disc Diffusion Assay
4.8. MIC/MBC Determination
4.9. Antibiofilm Activity of H. siliquosa Crude Extracts
4.10. TLC Overlays-Bioassay Guided Fractionation
4.11. Confocal Laser Scanning Microscopy of S. aureus Biofilms Treated with H. siliquosa Crude Extracts
4.12. Extract Toxicity Screen Using the Galleria Mellonella Model
4.13. Bioassay Guided Fractionation of Antibiofilm Bioactives from Halidrys siliquosa
5. Conclusions
Acknowledgments
Author Contributions
Conflicts of Interest
References
- Salta, M.; Wharton, J.A.; Blache, Y.; Stokes, K.R.; Briand, J.F. Marine Biofilms on artificial surfaces: Structure and dynamics. Environ. Microbiol. 2013. [Google Scholar] [CrossRef] [PubMed]
- Wahl, M. Marine, Epibiosis. I. Fouling and antifouling: Some basic aspects. Mar. Ecol. Prog. Ser. 1989, 58, 175–189. [Google Scholar] [CrossRef]
- Burgess, J.G.; Boyd, K.G.; Armstrong, E.; Jiang, Z.; Yan, L.; Berggren, M.; May, U.; Pisacane, T.; Granmo, A.; Adams, D.R. The Development of a marine natural product-based antifouling paint. Biofouling 2003, 19, 197–205. [Google Scholar] [CrossRef] [PubMed]
- Wahl, M.; Goecke, F.; Labes, A.; Dobretsov, S.; Weinberger, F. The second skin: Ecological role of epibiotic biofilms on marine organisms. Front. Microbiol. 2012, 3, 292. [Google Scholar] [CrossRef] [PubMed]
- Khandeparker, L.; Chandrashekar Anil, A.; Raghukumar, S. Relevance of biofilm bacteria in modulating the larval metamorphosis of Balanus amphitrite. FEMS Microbiol. Ecol. 2006, 58, 425–438. [Google Scholar] [CrossRef] [PubMed]
- Benhamed, S.; Guardiola, F.A.; Mars, M.; Esteban, M.A. Pathogen bacteria adhesion to skin mucus of fishes. Vet. Microbiol. 2014, 171, 1–12. [Google Scholar] [CrossRef] [PubMed]
- Jung, Y.C.; Bhushan, B. Wetting behavior of water and oil droplets in three-phase interfaces for hydrophobicity/philicity and oleophobicity/philicity. Langmuir 2009, 25, 14165–14173. [Google Scholar] [CrossRef] [PubMed]
- Devaraj, H.; Natarajan, A. Molecular mechanisms regulating molting in a Crustacean. FEBS J. 2006, 273, 839–846. [Google Scholar] [CrossRef] [PubMed]
- Givskov, M.; de Nys, R.; Manefield, M.; Gram, L.; Maximilien, R.; Eberl, L.; Molin, S.; Steinberg, P.D.; Kjelleberg, S. Eukaryotic interference with homoserine lactone-mediated prokaryotic signalling. J. Bacteriol. 1996, 178, 6618–6622. [Google Scholar] [PubMed]
- Hentzer, M.; Riedel, K.; Rasmussen, T.B.; Heydorn, A.; Andersen, J.B.; Parsek, M.R.; Rice, S.A.; Eberl, L.; Molin, S.; Hoiby, N.; et al. Inhibition of quorum sensing in Pseudomonas aeruginosa biofilm bacteria by a halogenated furanone compound. Microbiology 2002, 148, 87–102. [Google Scholar] [PubMed]
- Manefield, M.; Rasmussen, T.B.; Henzter, M.; Andersen, J.B.; Steinberg, P.; Kjelleberg, S.; Givskov, M. Halogenated furanones inhibit quorum sensing through accelerated LuxR turnover. Microbiology 2002, 148, 1119–1127. [Google Scholar] [PubMed]
- Marechala, J.P.; Culioli, G.; Hellio, C.; Thomas-Guyonc, H.; Callowd, M.E.; Clare, A.S.; Ortalo-Magne, A. Seasonal variation in antifouling activity of crude extracts of the brown alga Bifurcaria bifurcata (Cys—Toseiraceae) againts cyprids of Balanus amphitrite and the marine bacteria Cobetia marina and Pseualteromonas haloplanktis. J. Exp. Mar. biol. Ecol. 2004, 313, 27–62. [Google Scholar]
- Ganti, V.S.; Kim, K.H.; Bhattarai, H.D.; Shin, H.W. Isolation and characterisation of some antifouling agents from the brown alga Sargassum confusum. J. Asian Nat. Prod. Res. 2006, 8, 309–315. [Google Scholar] [CrossRef] [PubMed]
- Bazes, A.; Silkina, A.; Douzenel, P.; Faÿ, F.; Kervarec, N.; Morin, D.; Berge, J.P.; Bourgougnon, N. Investigation of the antifouling co nstituents from the brown alga Sargassum muticum (Yendo) Fensholt. J. Appl. Phycol. 2009, 21, 395–403. [Google Scholar] [CrossRef]
- Manivannan, K.; Karthikai Devi, G.; Anantharaman, P.; Balasubramanian, T. Antimicrobial Potential of selected brown seaweeds from Vedalai Coastal Waters, Gulf of Mannar. Asian Pac. J. Trop. Biomed. 2011, 1, 114–120. [Google Scholar] [CrossRef]
- McClintock, J.B.; Baker, B.J. Marine Chemical Ecology; CRC Press: Boca Raton, FL, USA, 2001. [Google Scholar]
- Folmer, F.; Jaspars, M.; Dicato, M.; Diederich, M. Photosynthetic marine organisms as a source of anticancer compounds. Phytochem. Rev. 2010, 9, 557–579. [Google Scholar] [CrossRef]
- Challinor, H.; Wickens, S.M.; Clark, J.; Murphy, A. A Beginner’s Guide to Ireland’s Seashore; Sherkin Island Marine Station: Cork, Ireland, 2003. [Google Scholar]
- Spavieri, J.; Allmendinger, A.; Kaiser, M.; Casey, R.; Hingley-Wilson, S.; Lalvani, A.; Guiry, M.D.; Blunden, G.; Tasdemir, D. Antimycobacterial, antiprotozoal and cytotoxic potential of twenty-one brown algae (Phaeophyceae) from British and Irish Waters. Phytother. Res. 2010, 24, 1724–1729. [Google Scholar] [CrossRef] [PubMed]
- Culioli, G.; Ortalo-Magne, A.; Valls, R.; Hellio, C.; Clare, A.S.; Piovetti, L. Antifouling activity of meroditerpenoids from the marine brown alga Halidrys siliquosa. J. Nat. Prod. 2008, 71, 1121–1126. [Google Scholar] [CrossRef] [PubMed]
- Hornsey, I.S.; Hide, D. The production of antimicrobial compounds by British marine algae. IV Variation of antimicrobial activity with algal generation. Br. Phycol. J. 1985, 20, 21–25. [Google Scholar] [CrossRef]
- Hornsey, I.S.; Hide, D. The production of antimicrobial compounds by British marine algae II. Seasonal variation in production of antibiotics. Br. Phycol. J. 1976, 11, 63–67. [Google Scholar] [CrossRef]
- Schaudinn, C.; Stoodley, P.; Kainović, A.; O’Keeffe, T.; Costerton, B.; Robinson, D.; Baum, M.; Ehrlich, G.; Webster, P. Bacterial biofilms, other structures seen as mainstream concepts. Microbe 2007, 2, 231–237. [Google Scholar]
- Romling, U.; Balsalobre, C. Biofilm infections, their resilience to therapy and innovative treatment strategies. J. Intern. Med. 2012, 272, 541–561. [Google Scholar] [CrossRef] [PubMed]
- Costerton, J.W. Introduction to biofilm. Int. J. Antimicrob. Agents 1999, 11, 217–221. [Google Scholar] [CrossRef]
- Le Magrex-Debar, E.; Lemoine, J.; Gelle, M.P.; Jacquelin, L.F.; Choisy, C. Evaluation of biohazards in dehydrated biofilms on foodstuff packaging. Int. J. Food Microbiol. 2000, 55, 239–243. [Google Scholar] [CrossRef]
- Mah, T.F.; O’Toole, G.A. Mechanisms of biofilm resistance to antimicrobial agents. Trends Microbiol. 2001, 9, 34–39. [Google Scholar] [CrossRef]
- Stewart, P.S.; Costerton, J.W. Antibiotic resistance of bacteria in biofilms. Lancet 2001, 358, 135–138. [Google Scholar] [CrossRef]
- Dunne, W.M., Jr. Bacterial adhesion: seen any good biofilms lately? Clin. Microbiol. Rev. 2002, 15, 155–166. [Google Scholar] [CrossRef] [PubMed]
- Teitzel, G.M.; Parsek, M.R. Heavy metal resistance of biofilm and planktonic Pseudomonas aeruginosa. Appl. Environ. Microbiol. 2003, 69, 2313–2320. [Google Scholar] [CrossRef] [PubMed]
- Harrison, J.J.; Ceri, H.; Turner, R.J. Multimetal resistance and tolerance in microbial biofilms. Nat. Rev. Microbiol. 2007, 5, 928–938. [Google Scholar] [CrossRef] [PubMed]
- McNeill, K.; Hamilton, I.R. Acid Tolerance response of biofilm cells of Streptococcus mutans. FEMS Microbiol. Lett. 2003, 221, 25–30. [Google Scholar] [CrossRef]
- Tait, K.; Skillman, L.C.; Sutherland, W. The efficacy of bacteriophage as a method of biofilm eradication. Biofouling 2002, 18, 305–311. [Google Scholar] [CrossRef]
- Leid, J.G.; Shirtliff, M.E.; Costerton, J.W.; Stoodley, P. Human leukocytes adhere to, penetrate, and respond to Staphylococcus aureus biofilms. Infect. Immun. 2002, 70, 6339–6345. [Google Scholar] [CrossRef] [PubMed]
- Matz, C. Biofilms as refuge against predation. In The Biofilm Mode of Life Mechanisms and Adaptations, 1st ed.; Kjelleberg, S., Givskov, M., Eds.; Horizon Bioscience: Norfolk, UK, 2007; pp. 195–214. [Google Scholar]
- Hoiby, N.; Bjarnsholt, T.; Givskov, M.; Molin, S.; Ciofu, O. Antibiotic resistance of bacterial biofilms. Int. J. Antimicrob. Agents 2010, 35, 322–332. [Google Scholar] [CrossRef] [PubMed]
- Bjarnsholt, T. The role of bacterial biofilms in chronic infections. APMIS Suppl. 2013, 136, 1–51. [Google Scholar] [CrossRef] [PubMed]
- Ceri, H.; Olson, M.E.; Turner, R.J. Needed, new paradigms in antibiotic development. Expert Opin. Pharmacother. 2010, 11, 1233–1237. [Google Scholar] [CrossRef] [PubMed]
- Hoiby, N.; Ciofu, O.; Johansen, H.K.; Song, Z.J.; Moser, C.; Jensen, P.O.; Molin, S.; Givskov, M.; Tolker-Nielsen, T.; Bjarnsholt, T. The clinical impact of bacterial biofilms. Int. J. Oral Sci. 2011, 3, 55–65. [Google Scholar] [CrossRef] [PubMed]
- Ready, D.; Roberts, A.P.; Pratten, J.; Spratt, D.A.; Wilson, M.; Mullany, P. Composition and antibiotic resistance profile of microcosm dental plaques before and after exposure to tetracycline. J. Antimicrob. Chemother. 2002, 49, 769–775. [Google Scholar] [CrossRef] [PubMed]
- Appelbaum, P.C. Reduced glycopeptide susceptibility in methicillin-resistant Staphylococcus aureus (MRSA). Int. J. Antimicrob. Agents 2007, 30, 398–408. [Google Scholar] [CrossRef] [PubMed]
- Hawkey, P.M. The Growing burden of antimicrobial resistance. J. Antimicrob. Chemother. 2008, 62 (Suppl. 1), i1–i9. [Google Scholar] [CrossRef] [PubMed]
- Boucher, H.W.; Talbot, G.H.; Bradley, J.S.; Edwards, J.E.; Gilbert, D.; Rice, L.B.; Scheld, M.; Spellberg, B.; Bartlett, J. Bad bugs, no drugs: No ESKAPE! An update from the Infectious Diseases Society of America. Clin. Infect. Dis. 2009, 48, 1–12. [Google Scholar] [CrossRef] [PubMed]
- Pendleton, J.N.; Gorman, S.P.; Gilmore, B.F. Clinical relevance of the ESKAPE pathogens. Expert Rev. Anti. Infect. Ther. 2013, 11, 297–308. [Google Scholar] [CrossRef] [PubMed]
- Archer, N.K.; Mazaitis, M.J.; Costerton, J.W.; Leid, J.G.; Powers, M.E.; Shirtliff, M.E. Staphylococcus aureus biofilms: Properties, regulation and roles in human disease. Virulence 2011, 2, 445–459. [Google Scholar] [CrossRef] [PubMed]
- Klevens, R.M.; Edwards, J.R.; Tenover, F.C.; McDonald, L.C.; Horan, T.; Gaynes, R. National nosocomial infections surveillance system. Changes in the epidemiology of methicillin-resistant Staphylococcus aureus in intensive care units in US hospitals, 1992–2003. Clin. Infect. Dis. 2006, 42, 389–391. [Google Scholar] [CrossRef] [PubMed]
- Boucher, H.W.; Corey, G.R. Epidemiology of methicillin-resistant Staphylococcus aureus. Clin. Infect. Dis. 2008, 46, S344–S349. [Google Scholar] [CrossRef] [PubMed]
- Costerton, J.W.; Montanaro, L.; Arciola, C.R. Biofilm in implant infections: Its production and regulation. Int. J. Artif. Organs 2005, 28, 1062–1068. [Google Scholar] [PubMed]
- Harvard Health Guide: Endocarditis. Drugs.com. Available online: http://www.drugs.com/health-guide/endocarditis.html (accessed on 30 May 2015).
- Talbot, G.H.; Bradley, J.; Edwards, J.E., Jr.; Gilbert, D.; Scheld, M.; Bartlett, J.G. Antimicrobial availability task force of the infectious diseases society of America. Bad bugs need drugs: An update on the development pipeline from the antimicrobial availability task force of the infectious diseases society of America. Clin. Infect. Dis. 2006, 42, 657–668. [Google Scholar] [CrossRef] [PubMed]
- Cotar, I. Quorum sensing inhibitors as anti-pathogenic drugs in the fight against Pseudomonas aeruginosa Infections. Clin. Microbiol. 2013, 2. [Google Scholar] [CrossRef]
- Brackman, G.; Cos, P.; Maes, L.; Nelis, H.J.; Coenye, T. Quorum sensing inhibitors increase the susceptibility of bacterial biofilms to antibiotics in vitro and in vivo. Antimicrob. Agents Chemother. 2011, 55, 2655–2661. [Google Scholar] [CrossRef] [PubMed]
- Christiaen, S.E.; Brackman, G.; Nelis, H.J.; Coenye, T. Isolation and identification of quorum quenching bacteria from environmental samples. J. Microbiol. Methods 2011, 87, 213–219. [Google Scholar] [CrossRef] [PubMed]
- Dobretsov, S.; Teplitski, M.; Bayer, M.; Gunasekera, S.; Proksch, P.; Paul, V.J. Inhibition of marine biofouling by bacterial quorum sensing inhibitors. Biofouling 2011, 27, 893–905. [Google Scholar] [CrossRef] [PubMed]
- Mellbye, B.; Schuster, M. The sociomicrobiology of antivirulence drug resistance: A proof of concept. mBio 2011, 2. [Google Scholar] [CrossRef] [PubMed]
- Atkinson, S.; Williams, P. Quorum sensing and social networking in the microbial world. Interface 2009, 6, 959–978. [Google Scholar] [CrossRef] [PubMed]
- Ng, W.L.; Perez, L.; Cong, J.; Semmelhack, M.F.; Bassler, B.L. Broad spectrum pro-quorum-sensing molecules as inhibitors of virulence in Vibrios. PLoS Pathog. 2012, 8, e1002767. [Google Scholar] [CrossRef] [PubMed]
- Rutherford, S.T.; Bassler, B.L. Bacterial quorum sensing: Its Role in virulence and possibilities for its control. Cold Spring Harb. Perspect. Med. 2012, 2. [Google Scholar] [CrossRef] [PubMed]
- Bassler, B.L.; Losick, R. Bacterially Speaking. Cell 2006, 125, 237–246. [Google Scholar] [CrossRef] [PubMed]
- Waters, C.M.; Bassler, B.L. Quorum sensing: Cell-to-cell communication in bacteria. Annu. Rev. Cell Dev. Biol. 2005, 21, 319–346. [Google Scholar] [CrossRef] [PubMed]
- Busetti, A.; Shaw, G.; Megaw, J.; Gorman, S.P.; Maggs, C.A.; Gilmore, B.F. Marine-derived quorum-sensing inhibitory activities enhance the antibacterial efficacy of tobramycin against Pseudomonas aeruginosa. Mar. Drugs 2014, 13, 1–28. [Google Scholar] [CrossRef] [PubMed]
- Rasmussen, T.B.; Givskov, M. Quorum-sensing inhibitors as anti-pathogenic drugs. Int. J. Med. Microbiol. 2006, 296, 149–161. [Google Scholar] [CrossRef] [PubMed]
- Defoirdt, T.; Boon, N.; Bossier, P. Can bacteria evolve resistance to quorum sensing disruption? PLoS Pathog. 2010, 6, e1000989. [Google Scholar] [CrossRef] [PubMed]
- Desbois, A.P.; Coote, P.J. Utility of greater wax moth larva (Galleria mellonella) for evaluating the toxicity and efficacy of new antimicrobial agents. Adv. Appl. Microbiol. 2012, 78, 25–53. [Google Scholar] [PubMed]
- McLean, R.J.; Pierson, L.S., III; Fuqua, C. A Simple screening protocol for the identification of quorum signal antagonists. J. Microbiol. Methods 2004, 58, 351–360. [Google Scholar] [CrossRef] [PubMed]
- NIH Research on Microbial Biofilms. Available online: http://grants.nih.gov/grants/guide/pa-files/PA-03-047.html (accessed on 30 May 2015).
- Lebeaux, D.; Chauhan, A.; Rendueles, O.; Beloin, C. From in vitro to in vivo models of bacterial biofilm-related infections. Pathogens 2013, 2, 288–356. [Google Scholar] [CrossRef] [PubMed]
- Costerton, J.W.; Stewart, P.S.; Greenberg, E.P. Bacterial biofilms: A common cause of persistent infections. Science 1999, 284, 1318–1322. [Google Scholar] [CrossRef] [PubMed]
- Lewis, K. Antibiotics: Recover the Lost Art of Drug Discovery. Nature 2012, 485, 439–440. [Google Scholar] [CrossRef] [PubMed]
- Conlon, B.P.; Nakayasu, E.S.; Fleck, L.E.; LaFleur, M.D.; Isabella, V.M.; Coleman, K.; Leonard, S.N.; Smith, R.D.; Adkins, J.N.; Lewis, K. Activated ClpP kills persisters and eradicates a chronic biofilm infection. Nature 2013, 503, 365–370. [Google Scholar] [CrossRef] [PubMed]
- Schumm, K.; Lam, T.B. Types of urethral catheters for management of short-term voiding problems in hospitalised adults. Cochrane Database Syst. Rev. 2008. [Google Scholar] [CrossRef]
- Jacobsen, S.M.; Shirtliff, M.E. Proteus mirabilis biofilms and catheter-associated urinary tract infections. Virulence 2011, 2, 460–465. [Google Scholar] [CrossRef] [PubMed]
- Francolini, I.; Donelli, G. Prevention and control of biofilm-based medical-device-related infections. FEMS Immunol. Med. Microbiol. 2010, 59, 227–238. [Google Scholar] [CrossRef] [PubMed]
- Smith, R.S.; Zhang, Z.; Bouchard, M.; Li, J.; Lapp, H.S.; Brotske, G.R.; Lucchino, D.L.; Weaver, D.; Roth, L.A.; Coury, A.; et al. Vascular catheters with a nonleaching poly-sulfobetaine surface modification reduce thrombus formation and microbial attachment. Sci. Transl. Med. 2012, 4, 153–132. [Google Scholar] [CrossRef] [PubMed]
- Gales, A.C.; Jones, R.N.; Forward, K.R.; Liñares, J.; Sader, H.S.; Verhoef, J. Emerging importance of multidrug-resistant Acinetobacter species and Stenotrophomonas maltophilia as pathogens in seriously ill patients: Geographic patterns, epidemiological features, and trends in the SENTRY antimicrobial surveillance program (1997–1999). Clin. Infect. Dis. 2001, 32, S104–S113. [Google Scholar] [PubMed]
- Brooke, J.S. Stenotrophomonas maltophilia: An emerging global opportunistic pathogen. Clin. Microbiol. Rev. 2012, 25, 2–41. [Google Scholar] [CrossRef] [PubMed]
- Hentzer, M.; Wu, H.; Andersen, J.B.; Riedel, K.; Rasmussen, T.B.; Bagge, N.; Kumar, N.; Schembri, M.A.; Song, Z.; Kristoffersen, P.; et al. Attenuation of Pseudomonas aeruginosa virulence by quorum sensing inhibitors. EMBO J. 2003, 22, 3803–3815. [Google Scholar] [CrossRef] [PubMed]
- Rasmussen, T.B.; Manefield, M.; Andersen, J.B.; Eberl, L.; Anthoni, U.; Christophersen, C.; Steinberg, P.; Kjelleberg, S.; Givskov, M. How Delisea pulchra furanones affect quorum sensing and swarming motility in Serratia liquefaciens MG1. Microbiology 2000, 146, 3237–3244. [Google Scholar] [PubMed]
- Manefield, M.; Welch, M.; Givskov, M.; Salmond, G.P.; Kjelleberg, S. Halogenated furanones from the red alga, Delisea pulchra, inhibit carbapenem antibiotic synthesis and exoenzyme virulence factor production in the phytopathogen Erwinia carotovora. FEMS Microbiol. Lett. 2001, 205, 131–138. [Google Scholar] [CrossRef] [PubMed]
- Williamson, N.R.; Fineran, P.C.; Leeper, F.J.; Salmond, G.P. The biosynthesis and regulation of bacterial prodiginines. Nat. Rev. Microbiol. 2006, 4, 887–899. [Google Scholar] [CrossRef] [PubMed]
- De Kievit, T.R.; Iglewski, B.H. Bacterial quorum sensing in pathogenic relationships. Infect. Immun. 2000, 68, 4839–4849. [Google Scholar] [CrossRef] [PubMed]
- Wagner, V.E.; Bushnell, D.; Passador, L.; Brooks, A.I.; Iglewski, B.H. Microarray analysis of Pseudomonas aeruginosa quorum-sensing regulons: Effects of growth phase and environment. J. Bacteriol. 2003, 185, 2080–2095. [Google Scholar] [CrossRef] [PubMed]
- Desbois, A.P.; Coote, P.J. Wax moth larva (Galleria mellonella): An in vivo model for assessing the efficacy of antistaphylococcal agents. J. Antimicrob. Chemother. 2011, 66, 1785–1790. [Google Scholar] [CrossRef] [PubMed]
- Bauer, A.W.; Kirby, W.M.; Sherris, J.C.; Turck, M. Antibiotic susceptibility testing by a standardized single disk method. Am. J. Clin. Pathol. 1966, 45, 493–496. [Google Scholar] [PubMed]
- Pompilio, A.; Catavitello, C.; Picciani, C.; Confalone, P.; Piccolomini, R.; Savini, V.; Fiscarelli, E.; D’Antonio, D.; di Bonaventura, G. Subinhibitory concentrations of moxifloxacin decrease adhesion and biofilm formation of Stenotrophomonas maltophilia from cystic fibrosis. J. Med. Microbiol. 2010, 59, 76–81. [Google Scholar] [CrossRef] [PubMed]
- Spicuzza, L.; Sciuto, C.; Vitaliti, G.; di Dio, G.; Leonardi, S.; La Rosa, M. Emerging pathogens in cystic fibrosis: Ten years of follow-up in a cohort of patients. Eur. J. Clin. Microbiol. Infect. Dis. 2009, 28, 191–195. [Google Scholar] [CrossRef] [PubMed]
© 2015 by the authors; licensee MDPI, Basel, Switzerland. This article is an open access article distributed under the terms and conditions of the Creative Commons Attribution license (http://creativecommons.org/licenses/by/4.0/).
Share and Cite
Busetti, A.; Thompson, T.P.; Tegazzini, D.; Megaw, J.; Maggs, C.A.; Gilmore, B.F. Antibiofilm Activity of the Brown Alga Halidrys siliquosa against Clinically Relevant Human Pathogens. Mar. Drugs 2015, 13, 3581-3605. https://doi.org/10.3390/md13063581
Busetti A, Thompson TP, Tegazzini D, Megaw J, Maggs CA, Gilmore BF. Antibiofilm Activity of the Brown Alga Halidrys siliquosa against Clinically Relevant Human Pathogens. Marine Drugs. 2015; 13(6):3581-3605. https://doi.org/10.3390/md13063581
Chicago/Turabian StyleBusetti, Alessandro, Thomas P. Thompson, Diana Tegazzini, Julianne Megaw, Christine A. Maggs, and Brendan F. Gilmore. 2015. "Antibiofilm Activity of the Brown Alga Halidrys siliquosa against Clinically Relevant Human Pathogens" Marine Drugs 13, no. 6: 3581-3605. https://doi.org/10.3390/md13063581
APA StyleBusetti, A., Thompson, T. P., Tegazzini, D., Megaw, J., Maggs, C. A., & Gilmore, B. F. (2015). Antibiofilm Activity of the Brown Alga Halidrys siliquosa against Clinically Relevant Human Pathogens. Marine Drugs, 13(6), 3581-3605. https://doi.org/10.3390/md13063581
